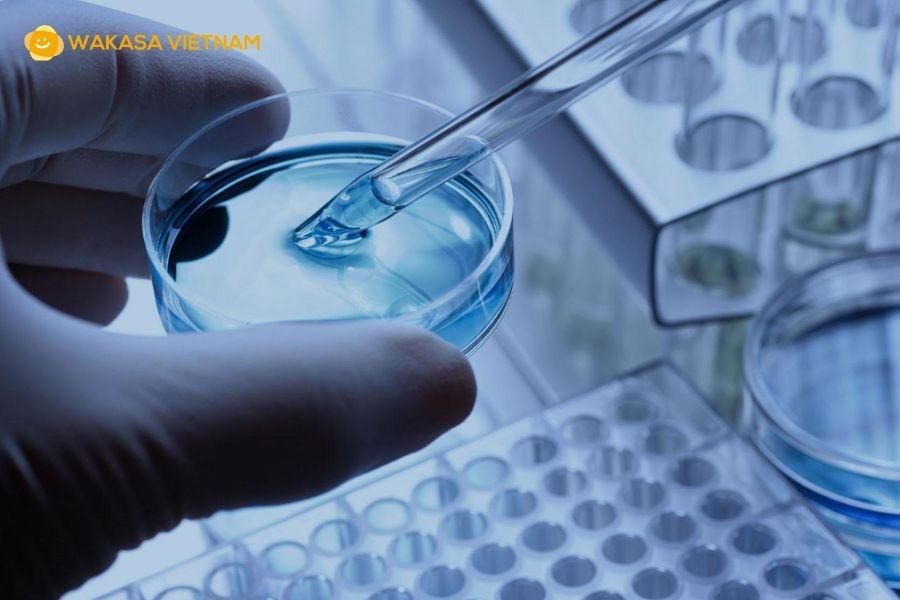

Chi phí làm IVF bao nhiêu? Cách tối ưu hóa chi phí tốt nhất cho các cặp đôi
Một câu hỏi khiến các cặp đôi trăn trở khi tìm hiểu về IVF là “Chi phí làm IVF bao nhiêu?” Vì sao cùng một phương pháp mà người này rẻ, người kia đắt? Sự chênh lệch ấy khiến nhiều cặp đôi vừa tò mò, vừa lo lắng liệu mình có đủ khả năng tài chính cho hành trình tìm con. Bài viết này sẽ giải thích rõ ràng và dễ hiểu nhất về chi phí làm IVF, vì sao mỗi người có mức phí khác nhau và cách tối ưu chi phí mà vẫn đảm bảo hiệu quả.
1. IVF là gì?
IVF (Thụ tinh ống nghiệm) là kỹ thuật cho phép kết hợp trứng và tinh trùng trong phòng thí nghiệm, sau đó đưa phôi khỏe mạnh vào tử cung người mẹ. Phương pháp này được xem là “phao cứu sinh” cho các trường hợp vô sinh hiếm muộn khó điều trị.

IVF là một trong những phương pháp điều trị hiếm muộn phổ biến hiện nay
Quy trình cơ bản của phương pháp IVF bao gồm các bước sau:
-
Kích thích buồng trứng - Sử dụng thuốc để buồng trứng sản xuất nhiều trứng trưởng thành
-
Chọc hút trứng và lấy tinh trùng
-
Thụ tinh - Trứng và tinh trùng được nuôi cấy trong đĩa petri để thụ tinh tạo thành phôi
-
Nuôi cấy và theo dõi phôi
-
Chuyển phôi - Phôi được đưa trở lại tử cung người mẹ để làm tổ và phát triển thành thai nhi
2. Vì sao ngày càng nhiều cặp đôi quan tâm đến “Chi phí làm IVF bao nhiêu”?
Nhờ tỷ lệ thành công cao của IVF mà ngày càng nhiều cặp đôi quan tâm về “Chi phí làm IVF bao nhiêu?”, bởi họ muốn biết liệu mình có đủ điều kiện tài chính hay không. Đây gần như là mối quan tâm số 1, vì IVF không chỉ là hành trình y khoa, mà còn là hành trình tài chính đòi hỏi chuẩn bị kỹ càng.
Trong thực tế, chi phí làm IVF bao nhiêu không có một con số chung. Không có bệnh nhân nào giống bệnh nhân nào, phác đồ nào giống phác đồ nào. Mỗi người sẽ được bác sĩ xây dựng một lộ trình hoàn toàn cá nhân hóa tùy vào:
-
Tuổi người mẹ (yếu tố ảnh hưởng mạnh nhất đến số thuốc kích trứng)
-
Số lượng trứng có thể thu được
-
Chất lượng tinh trùng và tỉ lệ tạo phôi
-
Tình trạng tử cung, niêm mạc, khả năng đáp ứng hormone
-
Có cần dùng các kỹ thuật bổ trợ như ICSI, PGT, hỗ trợ phôi thoát màng hay không
-
Bệnh viện, quốc gia thực hiện, vì mỗi nơi có mức giá và công nghệ khác nhau
-
Số lần chuyển phôi cần thiết, vì có người đậu thai ngay lần đầu, nhưng cũng có người cần 2-3 lần mới thành công
Chỉ cần một yếu tố nhỏ thay đổi, ví dụ AMH (Hormone kháng Muller) thấp hơn dự kiến hoặc niêm mạc phản ứng chậm, cũng khiến tổng chi phí làm IVF bao nhiêu tăng lên đáng kể. Chính vì vậy, khi tư vấn, bác sĩ thường chỉ đưa ra khoảng chi phí, chứ không thể đưa ra con số chính xác ngay từ đầu. Bởi phác đồ IVF là quá trình “vừa làm - vừa đáp ứng - vừa điều chỉnh”.
3. Các khoản chi phí cố định trong một chu kỳ IVF
Chi phí Thăm khám và xét nghiệm ban đầu
Đây là khoản chi phí tương đối cố định và bắt buộc. Mặc dù không chiếm tỷ trọng lớn trong tổng chi phí làm IVF bao nhiêu, giai đoạn này lại cực kỳ quan trọng để xác định phác đồ điều trị phù hợp nhất.

Chi phí thăm khám là chi phí cố định và bắt buộc với các cặp đôi
Chi phí này bao gồm các xét nghiệm đánh giá khả năng sinh sản của cả hai vợ chồng:
-
Xét nghiệm nội tiết tố
-
Phân tích tinh dịch đồ
-
Siêu âm tử cung - buồng trứng
-
Các xét nghiệm sàng lọc bệnh truyền nhiễm (HIV, viêm gan B, C,...)
Chi phí Thuốc kích thích buồng trứng
Đây là khoản chi phí biến đổi và chiếm từ 30% đến 50% tổng chi phí. Liều lượng và loại thuốc kích thích buồng trứng được sử dụng phụ thuộc hoàn toàn vào tuổi tác, chỉ số AMH và phản ứng của cơ thể người vợ với thuốc. Phụ nữ lớn tuổi hoặc có dự trữ buồng trứng thấp thường cần liều cao hơn, làm tăng đáng kể chi phí làm IVF bao nhiêu so với những người trẻ tuổi có sức khỏe sinh sản tốt.
Chi phí Quy trình chính và Thủ thuật phòng thí nghiệm
Khoản chi phí này là cốt lõi và tương đối cố định cho một chu kỳ IVF tiêu chuẩn. Nó bao gồm:
-
Chi phí thủ thuật chọc hút trứng
-
Chi phí Lấy tinh trùng
-
Chi phí Nuôi cấy phôi trong phòng thí nghiệm
-
Kỹ thuật tiêm tinh trùng vào bào tương noãn (ICSI)
Các phôi được nuôi cấy và bảo quản trong phòng thí nghiệm
Chi phí Lưu trữ
Nếu có nhiều phôi đạt chất lượng sau khi nuôi cấy trong phòng lab, bạn sẽ phải chi trả cho dịch vụ Đông lạnh phôi dư và Lưu trữ phôi trong các năm tiếp theo.
Ngoài ra, chi phí Sàng lọc di truyền tiền làm tổ (PGT-A/PGT-M) để kiểm tra các bất thường nhiễm sắc thể hoặc bệnh di truyền (đặc biệt với các cặp vợ chồng lớn tuổi) là một dịch vụ tùy chọn nhưng có mức giá khá cao.
Chi phí Chuyển phôi và Thuốc hỗ trợ
Đây là chi phí cố định cho quy trình chuyển phôi vào tử cung. Nếu chuyển phôi tươi (ngay trong chu kỳ kích trứng), chi phí này sẽ được tính kèm. Nếu chuyển phôi đông lạnh, sẽ có thêm chi phí Chuẩn bị nội mạc tử cung và chi phí cho các loại thuốc hỗ trợ nội tiết tố sau khi chuyển phôi để tăng khả năng phôi làm tổ thành công.
4. Lời khuyên tài chính: Cách tối ưu hóa chi phí để chuẩn bị tốt nhất
Lập kế hoạch tài chính chi tiết
-
Dự trù chi phí phát sinh: Luôn trích ra 20-30% tổng chi phí dự kiến để đối phó với những tình huống không lường trước (cần tăng liều thuốc, cần làm thêm xét nghiệm, phôi không phát triển tốt cần làm lại chu kỳ).
-
Hỏi rõ về gói dịch vụ: Yêu cầu bệnh viện liệt kê chi tiết các khoản đã bao gồm và chưa bao gồm (chi phí trữ phôi, chi phí PGT thường là dịch vụ riêng).

Lập kế hoạch để đảm bảo chi phí dự trù và phát sinh nếu có
Đánh giá chất lượng phòng Lab
Chất lượng phòng thí nghiệm là yếu tố quyết định tỷ lệ thành công. Việc chọn một phòng lab kém chất lượng để tiết kiệm chi phí có thể dẫn đến thất bại, và cuối cùng bạn vẫn phải trả chi phí cao hơn vì phải làm lại nhiều lần.
Cân nhắc lựa chọn đối tác quốc tế uy tín
Nếu bạn quyết định tìm kiếm chất lượng dịch vụ cao cấp và tỷ lệ thành công vượt trội ở nước ngoài. Việc có một đối tác tư vấn và hỗ trợ đáng tin cậy là vô cùng quan trọng để kiểm soát chi phí làm IVF bao nhiêu và tránh những chi phí phát sinh không cần thiết.
5. WAKASA Việt Nam - Đối tác hỗ trợ thụ tinh ống nghiệm quốc tế với chi phí minh bạch
WAKASA Việt Nam là đơn vị tư vấn và đối tác chiến lược uy tín của nhiều bệnh viện, trung tâm IVF quốc tế hàng đầu tại các quốc gia có công nghệ hỗ trợ sinh sản tiên tiến như Nhật Bản, Đài Loan, Thái Lan, Singapore,... mang đến:
-
Tư vấn chi phí minh bạch, dễ dàng xác định chi phí làm IVF bao nhiêu trước khi quyết định
-
Hỗ trợ phiên dịch, hồ sơ y tế và đặt lịch nhanh với các chuyên gia IVF top đầu
-
Quy trình tối ưu cho bệnh nhân Việt Nam, hạn chế đi lại nhiều lần
-
Theo dõi trước - trong và sau điều trị, đảm bảo kết nối thông suốt với bác sĩ nước ngoài
-
Đồng hành trọn gói, giúp bệnh nhân nắm rõ tổng chi phí làm IVF bao nhiêu và chuẩn bị tài chính hợp lý
Chi phí làm IVF bao nhiêu không thể chỉ dựa vào một con số chung. Mỗi người có phác đồ, cơ địa và nhu cầu điều trị khác nhau. Điều bạn cần là hiểu rõ từng bước, từng loại chi phí và tìm đơn vị tư vấn uy tín. Việc lựa chọn WAKASA Việt Nam là bạn không chỉ đầu tư vào một chu kỳ IVF mà còn đầu tư vào một kế hoạch làm cha mẹ được tối ưu hóa về chất lượng, hiệu quả và kiểm soát tài chính.